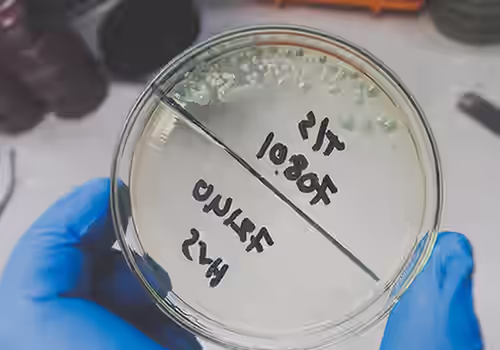
Enterococcus colony bacteria culture growth on a petri dish. What are fecal indicator bacteria?

Pace® Fecal Source Tracking Services
Pace® offers fecal source tracking services designed to help communities, businesses, and environmental professionals identify and address sources of contamination in water systems. Utilizing state-of-the-art techniques and rigorous analytical standards, our team can identify the presence of fecal indicator bacteria and help identify likely sources. Our fast, reliable analyses give you the actionable insights needed to protect public health and maintain regulatory compliance.
What Is Fecal Source Tracking?
Fecal Source Tracking is used to detect the presence and identify the origin of fecal contamination. While all fecal contamination can present health issues, human fecal matter is considered the most dangerous as it can carry harmful pathogens like bacteria (e.g., E.coli, Salmonella, Shigella), viruses (e.g., norovirus, hepatitis A, rotavirus), and parasites (e.g., Giardia and Cryptosporidium). In addition, understanding the source of the contamination can help in the creation of effective remediation strategies.
How Is Fecal Source Tracking Used?
Fecal Source Tracking can be useful in a variety of scenarios to aid health officials, environmental agencies, and water utilities in taking precise, informed actions to safeguard public health.
Fecal Source Tracking is widely used to ensure public safety in recreational waters, including public beaches and swimming pools. Contamination in these areas can stem from a variety of causes, such as sewage overflows, urban runoff, and animal waste.
Excessive precipitation and waterline breaks heighten the risk of sewage entering surface waters or stormwater systems. Fecal Source Tracking can rapidly detect the presence of fecal matter and identify its source, enabling emergency responders to issue the appropriate advisories, prioritize cleanup efforts, and prevent widespread outbreaks of waterborne diseases.
Groundwater is a vital source of drinking water in many regions. When contamination occurs due to failing septic systems or leaking sewer lines, Fecal Source Tracking can determine the source and inform corrective actions.
Runoff from fields and pastures can also lead to groundwater contamination. Identifying human versus animal sources is essential for preventing long-term exposure to pathogens and ensuring regulatory compliance for drinking water safety.
What Are Fecal Indicator Bacteria?
Fecal indicator bacteria provide a means of assessing the presence of fecal matter. However, since these bacteria are present in the digestive trac of all warm-blooded animals, including humans, they cannot be used to pinpoint the source of the contamination. There are three main types of fecal indicator bacteria:
Enterococci can be used to monitor fecal contamination in both marine and freshwater environments. In particular, recreational water samples are often evaluated for Enterococci as this bacterium is strongly associated with gastrointestinal illness.
Fecal coliform bacteria are a broad group of bacteria that thrive in the intestines of humans and animals. However, despite the name, a few organisms in this category are also found in the natural environment, so without more precise identification, fecal coliform testing is not a precise indicator of fecal contamination. Fecal coliforms are occasionally referenced in water quality regulations; however, testing for total coliforms and E. coli is more frequently mandated.
E. coli is a type of fecal coliform bacteria that is found only in the digestive system of warm-blooded animals, so it is one of the best fecal indicator bacteria for fecal contamination. E. coli analysis is almost always the preferred analysis for freshwater samples, including drinking water and recreational water, as the infection rate and severity of illness can be greater than that of Enterococci. As with other fecal indicator bacteria, more advanced analysis is required to determine the source of the contamination.
FOR MORE INFORMATION ON FECAL SOURCE TRACKING OR TO REQUEST A QUOTE
Determining the Source of Fecal Contamination
Bacteroides are a group of bacteria predominantly found in the intestines of warm-blooded animals. Unlike fecal indicator bacteria, Bacteroides species are highly host-specific, meaning certain strains are unique to humans while others are found only in particular animal species.
This specificity allows scientists to use molecular techniques, such as quantitative PCR assays (qPCR), to detect and identify Bacteroides DNA from various sources. By targeting genetic markers unique to human-associated Bacteroides, researchers can pinpoint contamination events, such as sewage or failing septic systems. Likewise, animal-specific markers can reveal agricultural runoff or wildlife contributions.
Additional FAQs
Here are a few of the more common questions we receive about Fecal Source Tracking. If you have additional questions, don’t hesitate to contact us.
Can Fecal Contamination Testing Be Performed on a Dry Surface?
Yes! Many bacteria, viruses, and parasites found in fecal matter can survive on dry surfaces, sometimes for days, weeks, or even longer, depending on the organism and environmental conditions. Specialized swabbing techniques can be used to sample dried surfaces for fecal contamination. Testing dry surfaces is particularly useful for flood remediation.
Can Total Coliform Analysis Be Used to Detect Fecal Contamination?
Total coliforms testing is often mandated for drinking water compliance and baseline safety. However, while total coliforms include bacteria found in the digestive tract, they also encompass species commonly present in soil, water, and vegetation that have no connection to fecal matter. Therefore, their presence alone does not necessarily indicate fecal contamination.
What Is the Difference Between Fecal Source Tracking (FST) And Microbial Source Tracking (MST)?
Fecal Source Tracking is a specialized subset within the broader field of Microbial Source Tracking, which encompasses analysis of a diverse range of microorganisms beyond those associated with fecal contamination. Examples include environmental bacteria (e.g., Pseudomonas, Legionella), cyanobacteria responsible for harmful algal blooms, industrially relevant microbes, and fungi or molds. Additionally, Microbial Source Tracking can be used to detect and identify antibiotic-resistant bacteria and microbes involved in natural or man-made pollution events, such as those originating from soil, decaying vegetation, wastewater effluent, or industrial runoff.